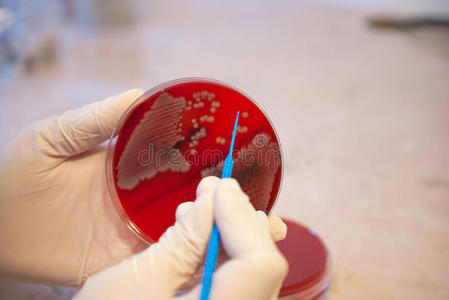
实验室医生拿着接种环和大肠埃希菌培养皿.医学实验室概念照片
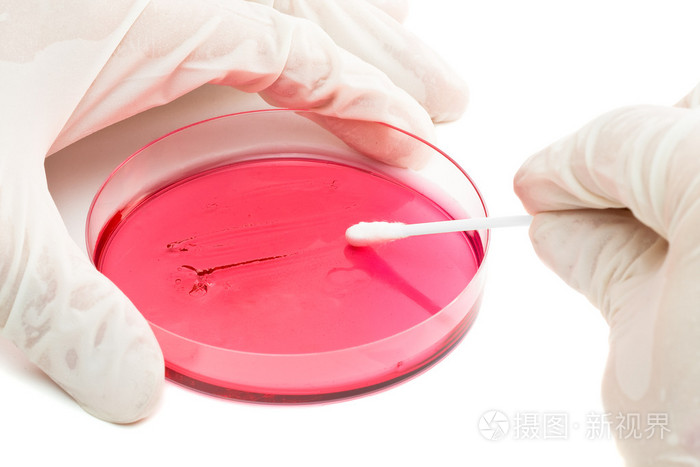
入培养皿的细菌样本接种

培养皿接种

实验室医生拿着接种环和大肠埃希菌培养皿.医学实验室概念照片
图片尺寸449x300
孤立白色背景培养皿中的化学研究在微生物学实验室准备盘子接种板疫苗
图片尺寸700x467
微生物学家手培养培养皿白衣接种循环,在高压釜旁边
图片尺寸700x467
基(简称菌种管)与待接种的新鲜斜面培养基(简称接种管)持在左手拇指
图片尺寸598x315
标本接种
图片尺寸2000x2667
微生物学家手培养培养皿白衣接种循环在高压釜旁边
图片尺寸700x467
微生物学家手培养培养皿白衣接种循环,在高压釜旁边
图片尺寸700x467
90mm平皿培养涂布接种操作介绍
图片尺寸640x360
在实验室由科学家手工用培养皿接种环培养
图片尺寸800x1200
接触皿涂布接种操作介绍
图片尺寸640x360
将标本接种于各种琼脂平板上进行培养
图片尺寸1440x1080
研究人员将接种到培养基中的微生物
图片尺寸1200x800
2 涂布方法: 将菌悬液小心滴在平板培养基表面中央位置(图3-8),右手
图片尺寸574x458
微生物接种片段
图片尺寸1528x1200
拿去培养,等着看成果!
图片尺寸2000x2667
小心翼翼地掀开培养皿,用蘸好菌液的接种环在培养皿上作画.
图片尺寸1080x720
入培养皿的细菌样本接种
图片尺寸700x467
琼脂培养基细菌接种在试管琼脂培养基上使用接种环由科学家实验室技术
图片尺寸450x300
微生物实验室中科学家实验室技术员接种环培养板细菌接种研究
图片尺寸700x467
科研人员在培养基上接种
图片尺寸710x481